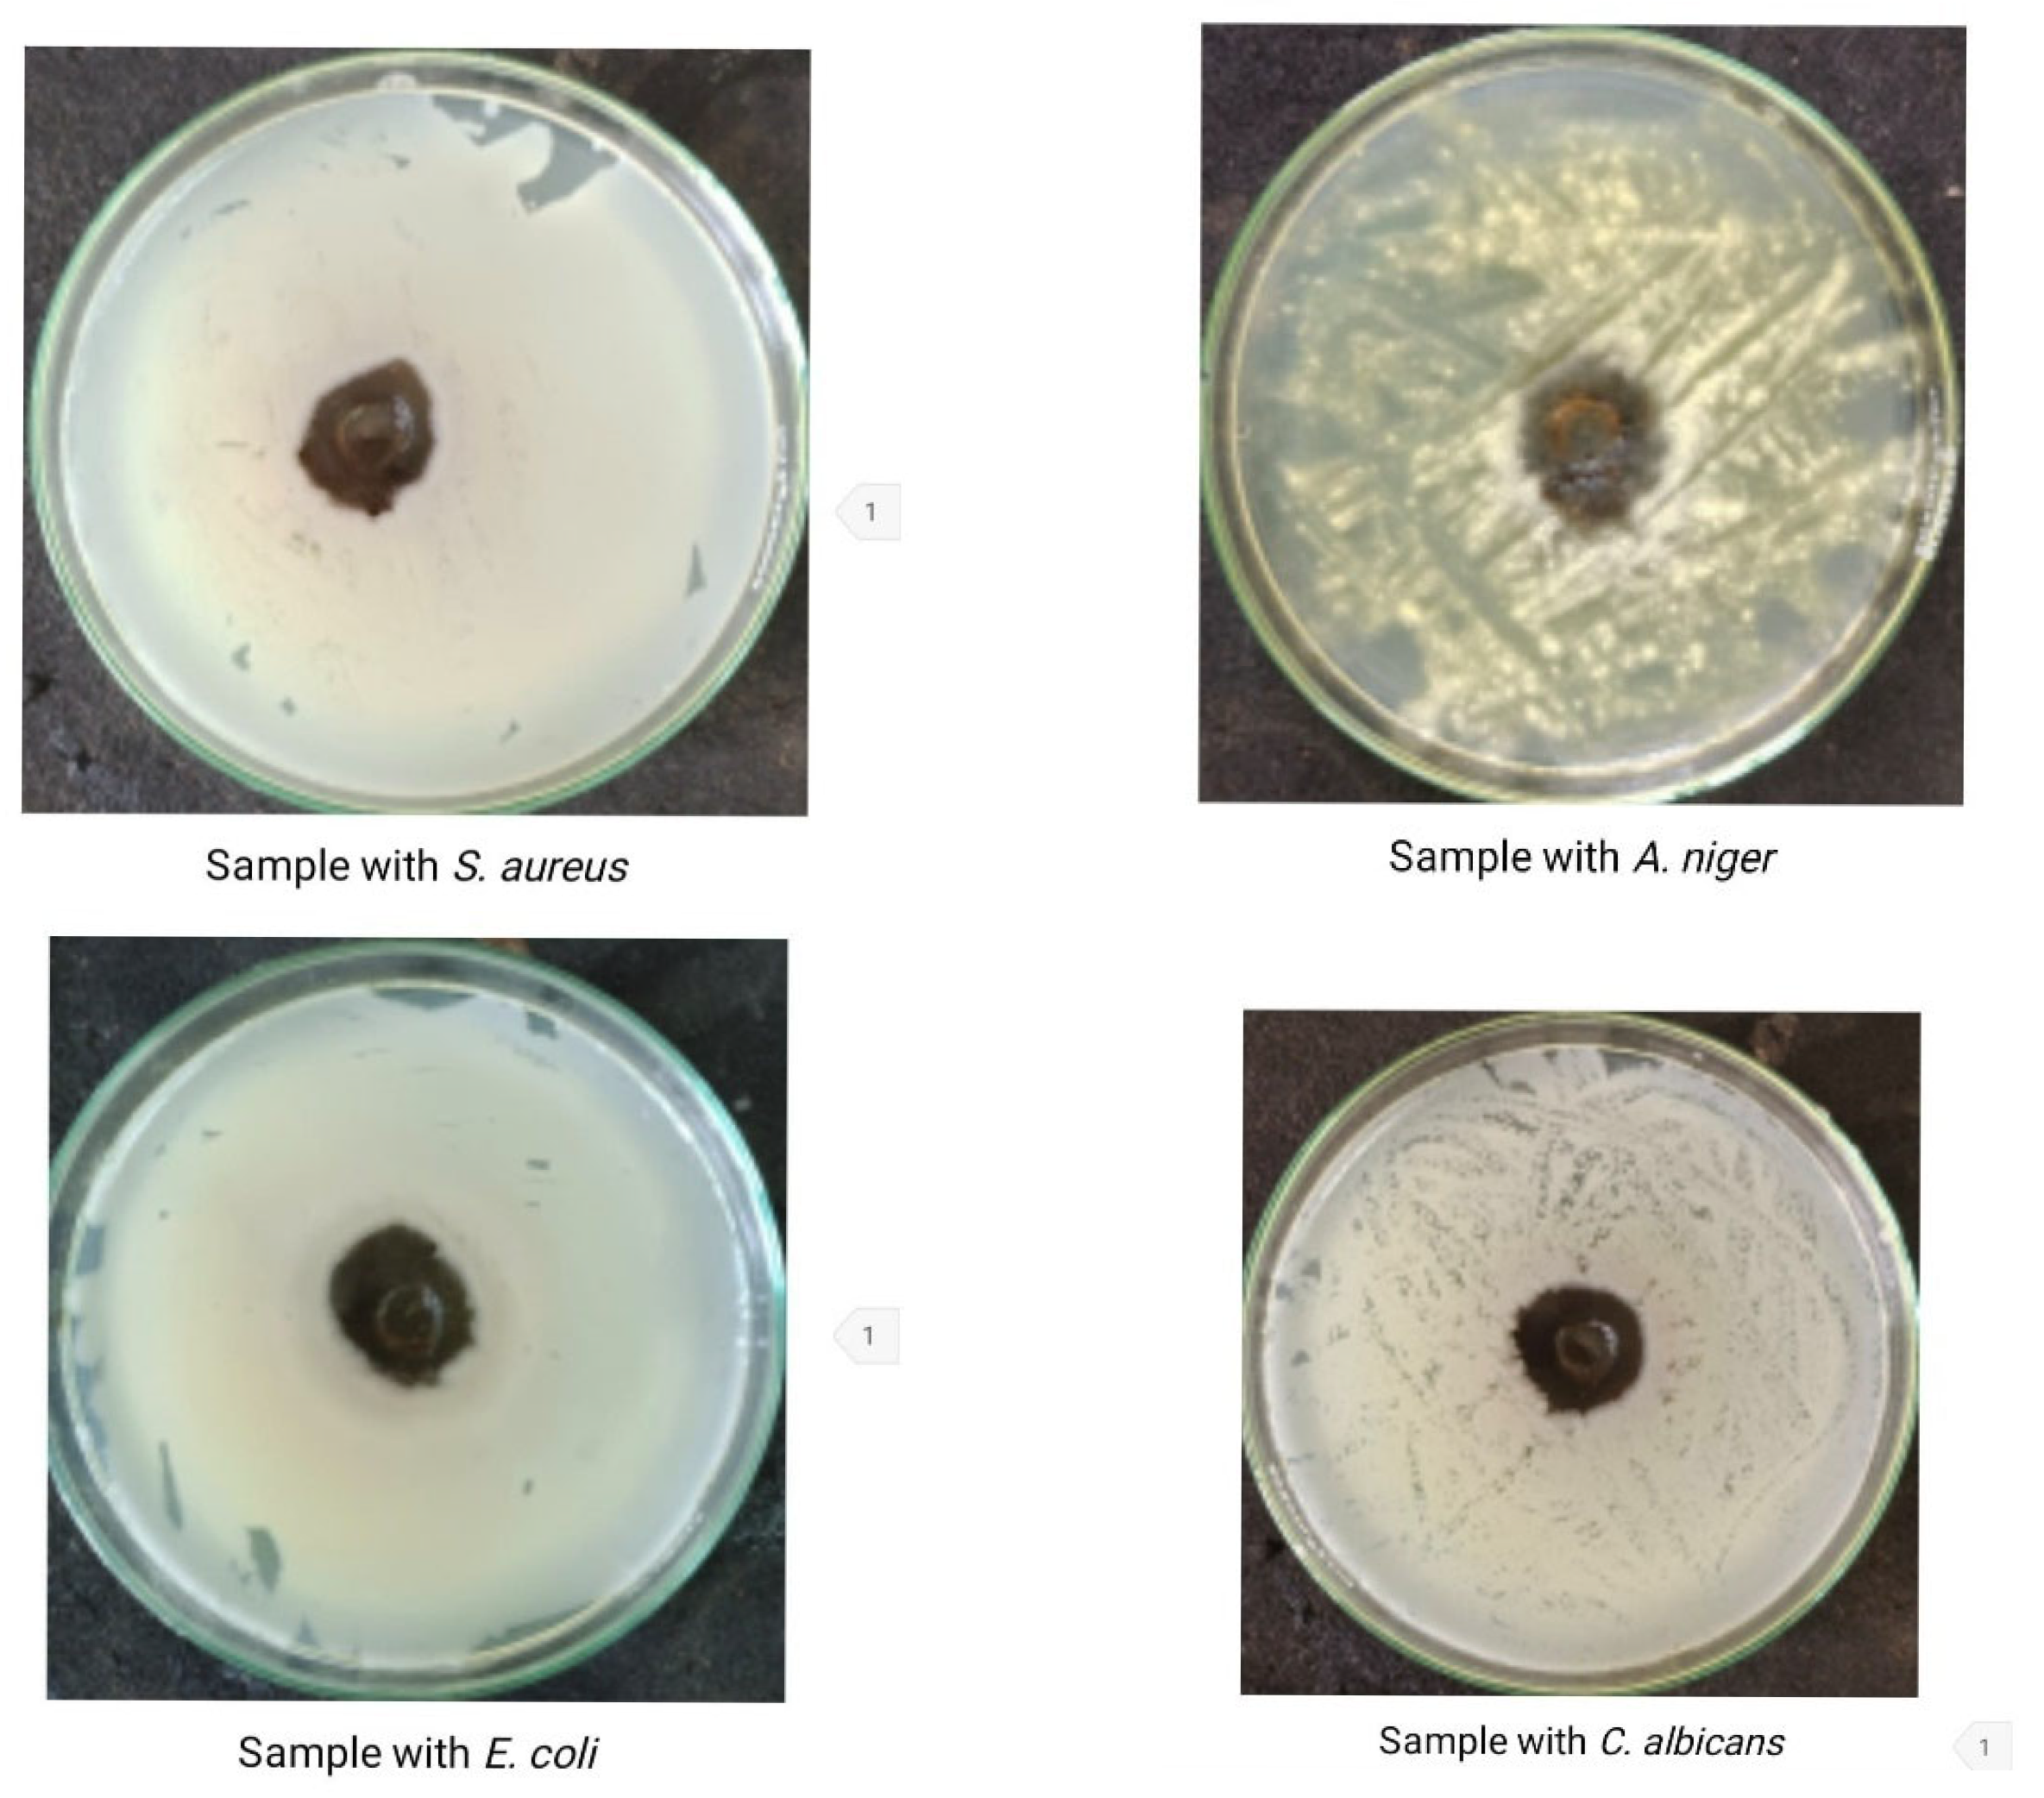
Processes 13 03453 g006 Processes 13 03453 g006

Production of Natural Pigment from Bacillus subtilis KU710517 Using Agro-Industrial Wastes and Application in Dyeing of Wool Fabrics
Abstract
1. Introduction
2. Materials and Methods
2.1. Microorganism
2.2. The Solid Waste Used for Pigment Production
2.3. Fabric Used
2.4. Production of Pigment
2.5. pH Adjustment
2.6. Dyeing of Wool Fabrics
2.7. Color Strength and Color Parameters Measurements
2.8. Fastness Testing
2.9. Antimicrobial Test
2.10. Partial Characterization of Bacillus subtilis KU710517 Pigment
2.10.1. FTIR Spectroscopy (Fourier Transform Infrared Spectroscopy)
2.10.2. HPLC Analysis
2.11. Statistical Analysis
3. Results
3.1. Screening for Pigment Produced by Bacillus subtilis KU710517 on Liquid Media with Different Waste Materials
3.2. Effect of Wheat Bran and Molokhia Stems Concentration in the Synthetic Liquid Medium on the Color Strength (K/S) of Dyed Wool Fabrics
3.3. Effect of Wheat Bran and Molokhia Stem Concentration in Water on the Color Strength (K/S) and Color Parameters of Dyed Wool Fabric
3.4. Fastness Properties of Dyed Wool Fabric at Optimum Conditions
3.5. Antimicrobial Activity of the Bacillus subtilis KU710517 Pigment
3.6. Partial Characterization of Bacillus subtilis KU710517 Pigment
3.6.1. FTIR Spectroscopy
3.6.2. HPLC Analysis
4. Discussion
5. Conclusions
Author Contributions
Funding
Data Availability Statement
Acknowledgments
Conflicts of Interest
References
- Heredia-Guerrero, J.A.; Heredia, A.; Domínguez, E. Cutin from agro-waste as a raw material for the production of bioplastics. J. Exp. Bot. 2017, 68, 5401–5410. [Google Scholar] [CrossRef]
- Nayak, A.; Bhushan, B. An overview of the recent trends on the waste valorization techniques for food wastes. J. Environ. Manag. 2019, 233, 352–370. [Google Scholar] [CrossRef]
- Panesar, R.; Kaur, S.; Panesar, P.S. Production of microbial pigments utilizing agro-industrial waste: A review. Curr. Opin. Food Sci. 2015, 1, 70–76. [Google Scholar] [CrossRef]
- Zihare, L.; Spalvins, K.; Blumberga, D. Multi criteria analysis for products derived from agro-industrial by-products. Energy Procedia 2018, 147, 452–457. [Google Scholar] [CrossRef]
- Sen, T.; Barrow, C.J.; Deshmukh, S.K. Microbial pigments in the food industry—Challenges and the way forward. Front. Nutr. 2019, 6, 7. [Google Scholar] [CrossRef] [PubMed]
- Kumar, A.; Vishwakarma, H.S.; Singh, J.; Dwivedi, S.; Kumar, M. Microbial pigments: Production and their applications in various industries. Int. J. Pharm. Chem. Biol. Sci. 2015, 5, 203–212. Available online: https://www.ijpcbs.com/articles/microbial-pigments-production-and-their-applications-invarious-industries.pdf (accessed on 19 October 2025).
- Ahmad, W.A.; Ahmad, W.Y.W.; Zakaria, Z.A.; Yusof, N.Z. Application of Bacterial Pigments as Colorant. In Application of Bacterial Pigments as Colorant: The Malaysian Perspective; Springer: Berlin/Heidelberg, Germany, 2011; pp. 57–74. [Google Scholar] [CrossRef]
- Barnett, T.A.; Valenzuela, D.; Riner, S.; Hageman, J.H. Production by Bacillis subtilis of brown sporulation-associated pigments. Can. J. Microbiol. 1983, 29, 96–101. [Google Scholar] [CrossRef]
- Hoti, S.; Balaraman, K. Formation of melanin pigment by a mutant of Bacillus thuringiensis H-14. Microbiology 1993, 139, 2365–2369. [Google Scholar] [CrossRef]
- Liu, Y.T.; Sui, M.J.; Ji, D.D.; Wu, I.H.; Chou, C.C.; Chen, C.C. Protection from ultraviolet irradiation by melanin of mosquitocidal activity of Bacillus thuringiensis var. israelensis. J. Invertebr. Pathol. 1993, 62, 131–136. [Google Scholar] [CrossRef]
- Mitchell, C.; Iyer, S.; Skomurski, J.F.; Vary, J.C. Red pigment in Bacillus megaterium spores. Appl. Environ. Microbiol. 1986, 52, 64–67. [Google Scholar] [CrossRef]
- Venil, C.K.; Zakaria, Z.A.; Ahmad, W.A. Bacterial pigments and their applications. Process Biochem. 2013, 48, 1065–1079. [Google Scholar] [CrossRef]
- Moeller, R.; Horneck, G.; Facius, R.; Stackebrandt, E. Role of pigmentation in protecting Bacillus sp. endospores against environmental UV radiation. FEMS Microbiol. Ecol. 2005, 51, 231–236. [Google Scholar] [CrossRef]
- Jang, J.H.; van Soest, R.W.; Fusetani, N.; Matsunaga, S. Pseudoceratins A (Ia) and B (Ib), Antifungal Bicyclic Bromotyrosine-Derived Metabolites from the Marine Sponge Pseudoceratina purpurea. J. Org. Chem. 2007, 72, 1211–1217. [Google Scholar] [CrossRef]
- Wehaidy, H.R.; Abdel-Naby, M.; Shousha, W.G.; El Mallah, M.I.; Shawky, M.M. Optimization of the production and characterization of milk clotting enzyme from Bacillus subtilis isolated from marine sponge. Egypt. Pharm. J. 2016, 15, 158–166. [Google Scholar] [CrossRef]
- Parmar, R.S.; Singh, C. A comprehensive study of ecofriendly natural pigment and its applications. Biochem. Biophys. Rep. 2018, 13, 22–26. [Google Scholar] [CrossRef]
- Ali, A.M.; Keera, A.A.; Helmy, S.M.; Abd El-Nasser, N.H.; Ahmed, K.A.; El-Hennawi, H.M. Selection of Pigment (Melanin) production in Streptomyces and their application in Printing and Dyeing of Wool Fabrics. Res. J. Chem. Sci. 2011, 1, 22–28. Available online: https://www.isca.me/rjcs/Archives/v1/i5/ISCA_RJCS_04_2011_90.pdf (accessed on 21 October 2025).
- Chrysler, L. Methods of Test for Colour Fastness of Textiles and Leather, 7th ed.; British Standards Institution: London, UK, 1990; Available online: https://knowledge.bsigroup.com/products/methods-of-test-for-colour-fastness-of-textiles-and-leather (accessed on 19 October 2025).
- Abdou, E.S.; El-Hennawi, H.M.; Ahmed, K.A. Edible Coloured Printing Paste for Food Packaging Materials Using Carboxymethyl Cellulose/Chitosan nanoparticles Composite as Thickeners. Egypt. J. Chem. 2024, 67, 637–645. [Google Scholar] [CrossRef]
- Ahmed, K.; Shahin, A.; Ragheb, A.; El-Hennawi, H. A Facile Synthesis with One Step of Disperse Azo Dyes to be Applied as Nano-Inks in Textile Printing. Biointerface Res. Appl. Chem. 2021, 11, 11713–11723. [Google Scholar] [CrossRef]
- Ahmed, E.A.; Elgemeie, G.; Ahmed, K.A.-E. Microwave-assisted synthesis of disazothiazolone dyes as antibacterial agents and their application in polyester printing. Pigment Resin Technol. 2022, 51, 1–5. [Google Scholar] [CrossRef]
- ISO 105-X19:2020; Textiles—Tests for Colour Fastness—Part X19: Colour Fastness to Rubbing. ISO: Geneva, Switzerland, 2013. Available online: https://www.iso.org/standard/77287.html?utm_ (accessed on 21 October 2025).
- ISO 105-C06:2010; Textiles—Tests for Colour Fastness—Part C06: Colour Fastness to Domestic and Commercial Laundering. ISO: Geneva, Switzerland, 2010. Available online: https://www.iso.org/standard/51276.html?utm_ (accessed on 19 October 2025).
- ISO 105-E04:2013; Textiles—Tests for Colour Fastness—Part E04: Colour Fastness to Perspiration. ISO: Geneva, Switzerland, 2013. Available online: https://www.iso.org/standard/57973.html?utm_ (accessed on 19 October 2025).
- ISO 105-B02:2014; Textiles—Tests for Colour Fastness—Part B02: Colour Fastness to Artificial Light: Xenon Arc Fading Lamp Test. ISO: Geneva, Switzerland, 2014. Available online: https://www.iso.org/standard/65209.html?utm_ (accessed on 19 October 2025).
- Elsaba, Y.M.; El-Hennawi, H.M.; Ibrahim, M.M.; Wehaidy, H.R. Production of a novel laccase from Ceratorhiza hydrophila and assessing its potential in natural dye fixation and cytotoxicity against tumor cells. J. Genet. Eng. Biotechnol. 2023, 21, 14. [Google Scholar] [CrossRef] [PubMed]
- Tamam, E.; Fadda, A.A.; El-Sawy, E.R.; Abdel-Aziz, M.S.; Tawfik, E.H. Design, synthesis, antimicrobial and docking studies of benzothiazoles bearing pyrazole and pyrimidine moieties. ChemistrySelect 2023, 8, e202302468. [Google Scholar] [CrossRef]
- Ganeshpurkar, A.; Saluja, A.K. The pharmacological potential of rutin. Saudi Pharm. J. 2017, 25, 149–164. [Google Scholar] [CrossRef]
- Rodríguez-Valdovinos, K.Y.; Salgado-Garciglia, R.; Vázquez-Sánchez, M.; Álvarez-Bernal, D.; Oregel-Zamudio, E.; Ceja-Torres, L.F.; Medina-Medrano, J.R. Quantitative analysis of rutin by HPTLC and in vitro antioxidant and antibacterial activities of phenolic-rich extracts from Verbesina sphaerocephala. Plants 2021, 10, 475. [Google Scholar] [CrossRef]
- Jhanji, R.; Singh, A.; Kumar, A. Antibacterial potential of selected phytomolecules: An experimental study. Microbiol. Immunol. 2021, 65, 325–332. [Google Scholar] [CrossRef] [PubMed]
- Gopal, J.; Muthu, M.; Paul, D.; Kim, D.H.; Chun, S. Bactericidal activity of green tea extracts: The importance of catechin containing nano particles. Sci. Rep. 2016, 6, 19710. [Google Scholar] [CrossRef]
- Miao, M.; Xiang, L. Pharmacological action and potential targets of chlorogenic acid. Adv. Pharmacol. 2020, 87, 71–88. [Google Scholar] [CrossRef]
- Lou, Z.; Wang, H.; Zhu, S.; Ma, C.; Wang, Z. Antibacterial activity and mechanism of action of chlorogenic acid. J. Food Sci. 2011, 76, M398–M403. [Google Scholar] [CrossRef] [PubMed]
- Fernandes, F.H.A.; Salgado, H.R.N. Gallic acid: Review of the methods of determination and quantification. Crit. Rev. Anal. Chem. 2016, 46, 257–265. [Google Scholar] [CrossRef] [PubMed]
- Borges, A.; Ferreira, C.; Saavedra, M.J.; Simões, M. Antibacterial activity and mode of action of ferulic and gallic acids against pathogenic bacteria. Microb. Drug Resist. 2013, 19, 256–265. [Google Scholar] [CrossRef]
- Cheemanapalli Srinivasulu, C.S.; Mopuri Ramgopal, M.R.; Golla Ramanjaneyulu, G.R.; Anuradha, C.M.; Kumar, C.S. Syringic acid (SA)—A review of its occurrence, biosynthesis, pharmacological and industrial importance. Pharma Innov. J. 2018, 12, 2217–2225. [Google Scholar] [CrossRef]
- Kinoka, M. Potato and potato peels: A comprehensive review on potato peels nutritional composition, bioactive compounds and its application in the food industry. Pharma Innov. J. 2023, 12, 2217–2225. Available online: https://www.thepharmajournal.com/archives/2023/vol12issue7/PartZ/12-6-182-370.pdf (accessed on 19 October 2025).
- Mostafa, F.A.; Wehaidy, H.R.; Sharaf, S.; El-Hennawi, H.M.; Mahmoud, S.A.; Saleh, S.A. Aspergillus awamori MK788209 cellulase: Production, statistical optimization, pea peels saccharification and textile applications. Microb. Cell Factories 2024, 23, 11. [Google Scholar] [CrossRef]
- Ahmed, S.A.; Saleh, S.A.A.; Mostafa, F.A.; Abd El Aty, A.A.; Ammar, H.A.M. Characterization and valuable applications of xylanase from endophytic fungus Aspergillus terreus KP900973 isolated from Corchorus olitorius. Biocatal. Agric. Biotechnol. 2016, 7, 134–144. [Google Scholar] [CrossRef]
- Esposito, F.; Arlotti, G.; Bonifati, A.M.; Napolitano, A.; Vitale, D.; Fogliano, V. Antioxidant activity and dietary fibre in durum wheat bran by-products. Food Res. Int. 2005, 38, 1167–1173. [Google Scholar] [CrossRef]
- Teiba, I.I.; Mamdouh, I.; Yousef, M.I.; Hussein, A.; El-Bilawy, E.H. Antimicrobial activity of Monascus purpureus-derived red pigments against Salmonella typhimurium, Escherichia coli, and Enterococcus faecalis. AMB Express 2025, 15, 6. [Google Scholar] [CrossRef]
- Kazi, Z.; Hungund, B.S.; Yaradoddi, J.S.; Banapurmath, N.R.; Yusuf, A.A.; Kishore, K.L.; Soudagar, M.E.M.; Khan, T.M.Y.; Elfasakhany, A.; Buyondo, K.A. Production, characterization, and antimicrobial activity of pigment from Streptomyces species. J. Nanomater. 2022, 2022, 3962301. [Google Scholar] [CrossRef]
- Wang, Z.; Ding, Z.; Li, Z.; Ding, Y.; Jiang, F.; Liu, J. Antioxidant and antibacterial study of 10 flavonoids revealed rutin as a potential antibiofilm agent in Klebsiella pneumoniae strains isolated from hospitalized patients. Microb. Pathog. 2021, 159, 105121. [Google Scholar] [CrossRef] [PubMed]
- Yang, K.; Zhang, L.; Liao, P.; Xiao, Z.; Zhang, F.; Sindaye, D.; Xin, Z.; Tan, C.; Deng, J.; Yin, Y.; et al. Impact of gallic acid on gut health: Focus on the gut microbiome, immune response, and mechanisms of action. Front. Immunol. 2020, 11, 580208. [Google Scholar] [CrossRef] [PubMed]

| Liquid Medium * | Pigment Production |
|---|---|
| Water with potato peels | −ve |
| Synthetic medium with potato peels | −ve |
| Water with wheat bran | +ve |
| Synthetic medium with wheat bran | +ve |
| Water with molokhia stalks | +ve |
| Synthetic medium with molokhia stalks | +ve |
| Wheat Bran Concentration (%) | L* | a* | b* | ΔE |
|---|---|---|---|---|
| 1 | 60.9 | 2.4 | 13.23 | 50.1 |
| 2 | 64.4 | 2.78 | 14.7 | 70.55 |
| 3 | 69.9 | 3.1 | 15.35 | 72.38 |
| 4 | 70.2 | 3.5 | 16.6 | 73.8 |
| 5 | 73.5 | 4.2 | 20.7 | 75.6 |
| 6 | 71.4 | 4 | 17.1 | 74.9 |
| Molokhia Stem Concentration (%) | L* | a* | b* | ΔE |
|---|---|---|---|---|
| 1 | 72.2 | 3.0 | 17.6 | 76.8 |
| 2 | 74.5 | 4.2 | 21.8 | 79.6 |
| 3 | 77.2 | 4.9 | 22.8 | 80.6 |
| 4 | 80.1 | 6.1 | 30.6 | 85.9 |
| 5 | 78.4 | 5–8 | 29.3 | 82.3 |
| Wheat Bran Concentration (%) | L* | a* | b* | ΔE |
|---|---|---|---|---|
| 1 | 61.9 | 2.4 | 11.23 | 50.1 |
| 2 | 63 | 2.6 | 13.7 | 54.55 |
| 3 | 65.9 | 3.1 | 15.4 | 62.38 |
| 4 | 69.2 | 3.2 | 16.1 | 71.8 |
| 5 | 72.5 | 4.2 | 19.7 | 74.6 |
| 6 | 71.3 | 3.9 | 18.1 | 70.9 |
| Molokhia Stalk Concentration (%) | L* | a* | b* | ΔE |
|---|---|---|---|---|
| 1 | 59.7 | 1.4 | 9.23 | 50.1 |
| 2 | 62 | 1.6 | 10.7 | 54.55 |
| 3 | 64.9 | 2.1 | 12.4 | 62.38 |
| 4 | 71.2 | 4.2 | 14.1 | 71.8 |
| 5 | 75.5 | 4.78 | 14.7 | 74.6 |
| 6 | 80.3 | 4.9 | 16.1 | 70.9 |
| 7 | 78.9 | 2.4 | 11.23 | 70.1 |
| pH | L* | a* | b* | c | h | ΔE |
|---|---|---|---|---|---|---|
| 2 | 74.94 | 2.49 | 16.71 | 16.9 | 81.53 | 76.82 |
| 3 | 74.62 | 2.21 | 16.56 | 16.7 | 82.39 | 76.46 |
| 4 | 80.18 | 1.75 | 11.70 | 11.83 | 81.53 | 81.05 |
| 7 | 74.01 | 3.85 | 23.3 | 23.62 | 80.62 | 77.69 |
| 9 | 74.06 | 6.29 | 28.21 | 28.9 | 77.43 | 79.5 |
| 11 | 74.73 | 4.93 | 25.76 | 26.23 | 79.16 | 77.2 |
| pH | L* | a* | b* | c | h | ΔE |
|---|---|---|---|---|---|---|
| 2 | 68.29 | 1.75 | 17.95 | 18.04 | 84.43 | 80.34 |
| 3 | 69.39 | 3.07 | 23.42 | 32.62 | 82.52 | 82.83 |
| 4 | 69.99 | 3.10 | 18.29 | 18.55 | 80.38 | 72.38 |
| 7 | 75.1 | 6.3 | 21.9 | 24.7 | 78.5 | 73.8 |
| 9 | 73.10 | 3.85 | 29.4 | 28.35 | 29.62 | 82.15 |
| 11 | 78.05 | 4.51 | 27.39 | 27.76 | 80.66 | 79.84 |
| Sample | K/S | Rubbing Fastness | Washing Fastness | Perspiration Fastness | Light Fastness | |||||
|---|---|---|---|---|---|---|---|---|---|---|
| Wet | Dry | Alt | St | Acid | Alkaline | |||||
| Alt | St | Alt | St | |||||||
| Wool Fabric (100%) | ||||||||||
| 5% wheat bran | 6.39 | 3–4 | 4 | 4 | 4 | 4 | 4–5 | 4 | 4–5 | 5–6 |
| 6% molokhia stems | 6.98 | 3–4 | 4 | 4 | 4 | 4 | 4–5 | 4 | 4–5 | 5–6 |
| Test Microbe | Clear Zone (mm) |
|---|---|
| Staphylococcus aureus | 24 |
| Escherichia coli | 28 |
| Candida albicans | 26 |
| Aspergillus niger | 16 |
| Components | Area | Conc. (mg/mL) |
|---|---|---|
| Gallic acid | 471.47 | 345.20 |
| Chlorogenic acid | 341 35 | 475.65 |
| Catechin | 29.04 | 62.40 |
| Methyl gallate | 15.23 | 8 52 |
| Coffeic acid | 14.78 | 7.58 |
| Syringic acid | 32.83 | 19.31 |
| Rutin | 8.31 | 12.44 |
| Ellagic acid | 1.51 | 1.53 |
| Coumaric acid | 6.18 | 2.22 |
| Vanillin | 16.35 | 5.93 |
| Ferulic acid | 10.16 | 5.90 |
| Naringenin | 3.82 | 3.53 |
| Rosmarinic acid | 1.64 | 1.59 |
| Daidzein | 0.00 | 0.00 |
| Querectin | 0.00 | 0.00 |
| Cinnamic acid | 0.00 | 0.00 |
| Kaempferol | 0.00 | 0.00 |
| Hesperetin | 9.06 | 4.24 |
Disclaimer/Publisher’s Note: The statements, opinions and data contained in all publications are solely those of the individual author(s) and contributor(s) and not of MDPI and/or the editor(s). MDPI and/or the editor(s) disclaim responsibility for any injury to people or property resulting from any ideas, methods, instructions or products referred to in the content. |
© 2025 by the authors. Licensee MDPI, Basel, Switzerland. This article is an open access article distributed under the terms and conditions of the Creative Commons Attribution (CC BY) license (https://creativecommons.org/licenses/by/4.0/).
Share and Cite
Ahmed, K.A.; El-Hennawi, H.M.; Wehaidy, H.R. Production of Natural Pigment from Bacillus subtilis KU710517 Using Agro-Industrial Wastes and Application in Dyeing of Wool Fabrics. Processes 2025, 13, 3453. https://doi.org/10.3390/pr13113453
Ahmed KA, El-Hennawi HM, Wehaidy HR. Production of Natural Pigment from Bacillus subtilis KU710517 Using Agro-Industrial Wastes and Application in Dyeing of Wool Fabrics. Processes. 2025; 13(11):3453. https://doi.org/10.3390/pr13113453
Chicago/Turabian StyleAhmed, K. A., Heba M. El-Hennawi, and Hala R. Wehaidy. 2025. "Production of Natural Pigment from Bacillus subtilis KU710517 Using Agro-Industrial Wastes and Application in Dyeing of Wool Fabrics" Processes 13, no. 11: 3453. https://doi.org/10.3390/pr13113453
APA StyleAhmed, K. A., El-Hennawi, H. M., & Wehaidy, H. R. (2025). Production of Natural Pigment from Bacillus subtilis KU710517 Using Agro-Industrial Wastes and Application in Dyeing of Wool Fabrics. Processes, 13(11), 3453. https://doi.org/10.3390/pr13113453

